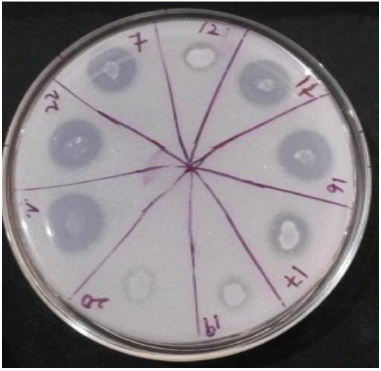
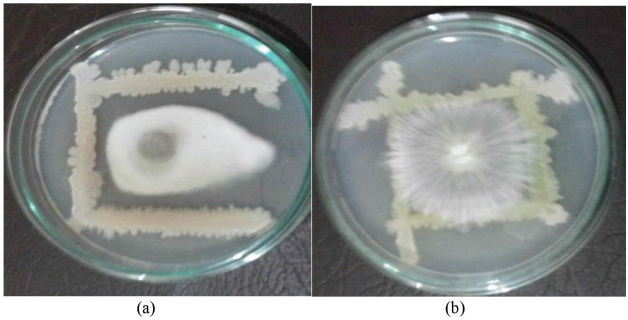

1. INTRODUCTION
For biological growth and development, phosphorous (P) is the second most important macronutrient after nitrogen [1]. It shows significant role in seed development, ramification of root, and increases plant strength, thereby imparting disease resistance capacity and vitality to the plants [2]. Deficiency of P in the plants results in wilting of leaves, delayed maturity, reduced yield, and stunted growth [3]. 0.05% (w/w) content of P is present in average soil, and the P available to the plants is 0.1% of the total P reserve, low solubility, and fixation in soil makes it less available to plants [4]. To achieve maximum productivity, chemical fertilizers rich in soluble forms of P is made available to the soil. However, soluble P can be easily precipitated and get converted to forms having low solubility such as Ca3(PO4)2, CaHPO4, AlPO4 and FePO4, and thus becomes unavailable to plants [5,6]. To circumvent P deficiency due to fixation, excess P was applied by farmers [7], less to be utilized by plants and forcing major portion to be accumulated in soil causing environmental and economic problem. [8,9], hence microbial application as biofertilizer is gaining momentum in agriculture [10], as availability of phosphates to plants and dynamics of P in soil is greatly influenced by soil microorganisms [11]. Dominant phosphate solubilizing bacteria (PSB) belongs to the Genera Bacillus, Pseudomonas, Enterobacter, Serratia, Pantoea, Flavobacterium etc. and dominant fungal genera are Penicillium and Aspergillus [12]. Majority of phosphate solubilizing microorganisms (PSM) solubilizes bound P complexes by extrusion of proton or by secretion of organic acids [13] which are most effective in releasing P from the soil [14].
In addition to P solubilization studies discussed above, soil microbes also supports growth of plant directly by N-fixation, ammonia production and by production of growth hormones for the plants. The indirect mechanism includes antibiotics production, extracellular production of enzymes which degrade cell wall of pathogens, hydrogen cyanide (HCN) and siderophore production, hence significantly promotes plant growth and improves plant health as evidenced by increase in vigor, seedling emergence and yield [15,16] Although PSMs are abundant in rhizosphere of most plants, but due to environmental factors such as pH, temperature, salinity and drought, survival and functionality of PSM is poor, hence making it necessary to isolate microbes from these conditions [15,17–19]. Therefore, the present research is designed to isolate and identify abiotic stress tolerant PSB from the arid regions of Telangana State, India and with other plant growth promoting (PGP) traits.
2. MATERIAL AND METHODS
2.1. Isolation of Rhizospheric PSB
The soil used for isolation of bacteria was collected from the agricultural fields of maize, rice, and ground nut in sterilized polythene bags, from the Mahbubnagar district of Telangana State, India. The serially diluted, soil samples were spread plated on nutrient agar and incubated at 30°C for 48 hours. Isolated, morphologically distinct colonies were selected and screened for their phosphate solubilization on National Botanical Research Institute Phosphate (NBRIP) agar medium [20] containing tri calcium phosphate (TCP) by point inoculation method. Plates were incubated at 30°C for 5 days. Colonies showing clear halo was selected and solubilization index was measured [21,22].
2.2. Quantitative Estimation of P Solubilized
Estimation of solubilized P was carried out by inoculating 1 ml of bacterial suspension (3 × 107 cells ml−1) in 150 ml Erlenmeyer flask containing 50 ml NBRIP broth medium, flask were incubated for 7 days at 30°C. After incubation, broth was centrifuged at 10,000 rpm for 10 minutes [23]. Released free P in supernatant was estimated by Ames method [24]
2.3. Screening for Plant Growth Promoting Activities
2.3.1. Indole acetic acid (IAA) production
One milliliter of bacterial suspension was inoculated in 50 ml of Luria Bertani broth supplemented with L-Tryptophan [100 micro gram (µg)/ml], flasks were incubated at 28 ± 2°C for 48 hours, samples were centrifuged at 10,000 rpm for 10 minutes, IAA was estimated in the supernatant by the standard method of Gorden and Weber [23,25].
2.3.2. Ammonia production
Ten milliliter peptone broth was inoculated with 200 µl cultures suspension (3 × 107 cells ml−1) of each PSB isolate and incubated at 30°C for 48 hours, 0.5 ml of Nessler’s reagent was added to each tube. Deep orange to brown color development was indicative as a positive test for ammonia production [26].
2.3.3. Production of HCN
The method of Bakker and Schipper was employed for qualitative testing of PSB isolates for HCN production. Glycine supplemented, nutrient agar medium plates were prepared. Inoculated media plates were covered with Whatman No.1 Filter paper (saturated with picric acid and sodium carbonates) and incubated for 4 days, filter paper developed brown color considered positive for HCN production [27].
2.3.4. Protease
PSB isolates were inoculated on skim milk agar medium plates by point inoculation method. The development of clear zone, around the colonies indicated positive proteolytic activity [28].
2.3.5. Cellulase
PSB isolates were screened by inoculating over-night grown cultures on cellulose Congo-Red agar media. Discoloration of Congo-red around the colonies were considered as positive for cellulose degradation [29].
2.3.6. Antifungal activity
Potato dextrose agar was used to screened antifungal activity of PSB isolates against plant pathogens Macrophomina phaseolina and Sclerotium rolfsii by dual culture method [30].
2.4. Plant Growth Promotion Study by Paper Towel Experiment
Maize seeds (Zea mays) Aparanji-i variety, were surface sterilized as per the method described by Soni et al. [31]. The seeds were then left immersed in each suspension of PSB isolates (1 × 108 cells ml−1) containing 1% carboxy-methylcellulose for 24 hours. Germination percentage was assessed as per International Seed Testing Association (ISTA, 1999) [32].
2.5. Identification
Microscopic identification was carried out by Gram staining, biochemical tests were performed as per the Bergey’s manual of systematic Bacteriology [33].
2.6. P-Solubilization Under Abiotic Stress
Prominent PSB isolates were assessed for their tolerance to abiotic stress such as temperature (45°C), pH (9), salinity (8%) and drought (−0.49 Matric Potential). All experiments were done in triplicates using 50 ml NBRIP broth supplemented with TCP in 150 ml conical flask under various stressed conditions and flask were incubated for 7 days on orbital shaker at 150 rev1 minutes. Volume of inoculum was adjusted to 3 × 10−7 ml−1 [30].
2.7. Molecular Identification and Scanning Electron Microscope (SEM) Imaging
Molecular identification of potential PSB isolate was done at Eurofins Genomics Pvt. Ltd., Bengaluru and SEM image of the same was taken at Physics Department, Osmania University, Hyderabad, India.
2.8. Statistical Analysis
All experiments were carried out in triplicates (n = 3). Standard deviation was used as a statistical tool and results are expressed as mean ± SD.
3. RESULTS AND DISCUSSION
3.1. Isolation of PSB
Microbial phosphate solubilization is important in promoting the plant growth. Several researchers have reported that inoculation of PSM in fields and greenhouse conditions promotes plant growth [23,34]. Bacterial ability to multiply fast compared to fungi and actinomycetes leads to dominate the phenomena of phosphate solubilization in soil [35].
Based on morphologically distinct colony characters on nutrient agar, forty nine bacterial isolates were selected and screened for P solubilization on NBRIP agar medium. Thirteen isolates solubilized TCP, under plate (Fig. 1) and broth assay. The highest P solubilization index was observed in MGnB10 that is 2.8, followed by MRB4 i.e. 2.6, but their respective P solubilization varied as MGnB10 solubilized 372 µg/ml, MRB4 solubilized 389 µg/ml, highest among all thirteen isolates. Earlier, research study done by Gupta et al. [36], Nautiyal [20], also supports our findings. Our results also reveals similarity in reduction of pH by PSB isolates, however there was variations in amount of P solubilized. For MMzB5 and MRB16 final pH was observed as 4.38, however solubilized P was estimated as 334 and 315 µg/ml, (Table 1) these results are very well corroborated with the findings of Gulati et al. [37] and Sujatha et al. [38], it indicates that decreasing pH due to organic acid production [39] is not the single factor for P solubilization. H+ translocation, chelating agents, production of inorganic acids etc., also take their share of solubilizing P in soil [4,40].
![]() | Figure 1: Solubilization of TCP on NBRIP agar medium by bacteria. [Click here to view] |
![]() | Table 1: Solubilization of TCP, qualitative and quantitative assay and pH change by PSB isolates. [Click here to view] |
3.2. Plant Growth Promoting Activities of PSB Isolate
Synthesis of biocontrol substances and plant growth regulators by PSM in addition to P solubilization enhances its applications as efficient bioinoculants [41]. Out of 13 PSB isolates, MMzB5, MRB4, and MRB16 were positive for all PGP activities (Table 2).
Out of 13, 12 isolates produced IAA, highest concentration 65 µg/ml produced by MRB4, lowest concentration was produced by MMzB12 20 µg/ml, IAA negative isolate is MGnB11. About 80% of rhizosphere microflora also owns the ability to produce auxins and our results are very well supported by the work of Patten and Glick [42]. All isolates were found to be positive for ammonia production, with variation in the intensity of yellow- brown color, six out of thirteen PSB isolates developed dark brown color, while other showed moderate ammonia production. Nine PSB isolates were positive for HCN production, only MRB4 showed strong HCN activity; others were moderate or weak producers. The role of IAA production [23,43], ammonia production [44,45], and HCN [46], and their subsequent impact on overall growth of plant have been reported. Nine PSB isolates were positive for protease enzyme and only six isolates showed zone of Congo red discoloration on cellulose Congo red agar media, indicates production of cellulase enzyme [15].
PSB isolates MMzB12, and MGnB11, do not show any antifungal activity, best among all is MRB4 (Fig. 2), other PSB isolates response towards M. phaseolina is good but against S. rolfsii very poor [30]
3.3. Plant Growth Promotion Studies on Maize
After PGP activities, PSB isolates were tested on maize (Z. mays), MRB4 showed maximum seed vigor index (4465) (Table 3) followed by MMzB5 (4232), our findings are similar with the work of Pacome et al. [12,23,31,47]. These results suggest that treatment with PSB is beneficial as it improves the growth of maize plant due to its ability to produce plant growth regulators in addition to solubilize phosphates [48].
![]() | Table 2: Plant growth promoting traits in PSB isolates. [Click here to view] |
![]() | Figure 2: Antifungal activity of MRB4, against (a) M. Phaseolina and (b) [Click here to view] |
3.4. Biochemical Identification
After performing Gram staining, motility and other biochemical test, PSB isolates were identified. MMzB5, MRB4, MRB7,MRB15,MGnB3, and MGnB16 belongs to the genus Bacillus (6), MMzB3, MMzB11, MRB16, MGnB9, and MGnB10 are from genus Pseudomonas (5), MMzB12 and MGnB11 from Klebsiella (Table 4). Bacillus, and Pseudomonas are considered as dominant genera of bacteria, present study is supported by the work of many researchers [1].
3.5. Stress Tolerance Studies
Agricultural needs are severely affected due to abiotic stress, such as temperature, pH, drought and salinity, an unavoidable problem which influenced the growth of plants. Microorganisms have unique property of adapting to changing environmental condition [49,50]. Successful utilization of these organisms in stressed ecosystems depends on their ability to resist and multiply under unfavorable environmental conditions, such as high temperatures, salt stress, heavy metal toxicity, mineral deficiency etc.
![]() | Table 3: Effect of PSB isolates on Z. mays. [Click here to view] |
![]() | Table 4: Morphological and biochemical characteristics of PSB isolates. [Click here to view] |
Based on the results of PGP activities and effect of PSB isolates on seedlings growth and seed germination, five best PSB isolates (Bacillus spp. MMzB5, MRB4, Pseudomonas spp. MMzB11, MRB16, and MGnB10) (Fig. 3) were screened for their P solubilization potential under various abiotic stress such as temperature (45°C), pH (9), salinity (8%) and drought (−0.49 Mpa). The isolates seemed generally well adapted to the environments, all five isolates demonstrated diverse levels of P solubilization. Bacillus sp. MRB4 was the best isolate among all as it shows P solubilization under all abiotic stressed condition followed by other Bacillus sp. MMzB5. As Bacillus spp possess the ability to produce endospore, it can combat against high temperature, salinity, and drought conditions more strongly compared to Pseudomonas isolates [30].
To be metabolically active and proliferate, microbes require a suitable temperature, but due to change in soil temperature, their physiological activities may get affected. In tropics, during summer, ambient temperature, and soil temperature vary between 35°C and 45°C, the ability of the organism to survive and grow at higher temperature in the soil as well as in the inoculant packets during transport and storage is one of the most desired characteristic. Bacillus spp. MRB4 solubilizes 193 µg/ml of P, followed by MMzB5 122 µg/ml. Although high temperature affect the P solubilization ability of the PSB isolates, however the inoculation of thermotolerant PSB isolates, improved the growth of Mung bean (Vigna radiata) as stated by Gaind and Gaur [51].
![]() | Figure 3: P solubilization under various abiotic stresses by five selected PSB isolates. (a) Temperature (45°C), (b) pH (9), (c) Salinity (8%), and (d) Drought (0.49 Mpa). Results represent the mean of three replicates ± standard deviation. [Click here to view] |
According to a study conducted by International Crops Research Institute for the Semi-arid Tropics in 2015, it was revealed that due to digging of bore well, salt is accumulating in soil, which is increasing soil pH [52], results in poor growth and survival of PSB [53]. All PSB isolates showed the P solubilization at alkaline pH 9, 181 µg/ml solubilized by Bacillus spp MRB4, followed by Pseudomonas spp. MRB16, MMzB11 solubilizes 141 and 106 µg/ml.
Salinity adversely affects the plant growth, development [54], and equally affects the survival and proliferation of microbes in soil and rhizosphere [55]. Bacillus spp. MRB4 solubilizes 124 µg/ml under 8% salinity stress, 385 µg/ml in control, other isolates did not show promising solubilization under salinity stress. In general, the amount of P released is found to decrease with increase in salt concentration and our results are in accordance with the work of Mohan et al. [56]. P solubilization was more in control than in medium supplemented with sodium chloride (NaCl).
In India, agricultural productivity is mostly limiting due to drought stress, which influences plant water relations, damaging plant growth. Inoculation of plants with drought tolerant beneficial microbe, improves the growth and tolerance of drought in plant as suggested by Ali et al. [19]. Out of five PSB isolates, three solubilizes P (MMzB5, MMzB11, and MRB4) under −0.49 Mpa and considerable solubilization was observed with isolate MRB4 90 µg/ml.
3.6. Molecular identification
Based on the potential to solubilize TCP under various abiotic stressed conditions and plant growth promoting traits, best isolate, namely, MRB4 (Bacillus spp.) was selected for molecular identification by 16S rRNA sequencing, showed highest similarity to Bacillus subtilis, sequence is submitted in NCB1 GenBank with accession number MK611797 (Fig. 4).
![]() | Figure 4: Evolutionary relationships of taxa the evolutionary history was inferred using the neighbor-joining method [57]. The optimal tree with the sum of branch length = 0.31480504 is shown. Next to the branches, the percentage of replicates trees in which the associated taxa clustered together in the bootstrap test (1,000 replicates) are shown [58]. The tree is drawn to scale, with branch lengths in the same units as those of the evolutionary distances used to deduce the phylogenetic tree. Kimura 2-parameter method was used for computing evolutionary distances [59] and are in the units of the number of base substitutions per site. 32 nucleotide sequences were analyzed. Positions containing gaps and missing data were eliminated. In the final dataset their were total 1,125 positions. MEGA7 was used for conducting evolutionary analyses Kumar et al. [60]. Only bootstrap values ≥ 70.0% are shown. [Click here to view] |
![]() | Figure 5: SEM image B. subtilis MRB4. [Click here to view] |
3.7. Scanning of electron microscopic image of B. subtilis
To know the surface morphology of efficient PSB isolate B. subtilis MRB4 better, Scanning electron image was taken in Department of Physics Osmania University, Hyderabad. Instrument used was Zeiss, with higher magnification. Rod shaped cells were observed (Fig. 5).
4. CONCLUSION
Bacillus subtilis MRB4, isolated from the rice field of Mahbubnagar, a district of Telangana state, India, is a promising plant growth promoter and a potential P solubilizer under stress (es) in vitro. Hence further evaluation of this bacterial strain is needed in greenhouse and field condition.
5. ACKNOWLEDGMENTS
The authors are thankful to the Principal and Management, Mumtaz Degree and PG College, Malakpet, Hyderabad, India, for providing the necessary facilities to carry out the research work.
6. CONFLICT OF INTEREST
The authors declare that there are no conflicts of interest.
7. FINANCIAL SUPPORT & SPONSORSHIP
None.
8. AUTHORS’ CONTRIBUTION
Authors listed have made a substantial, direct, and intellectual contribution to the work and approved it for publication.
9. LIST OF ABBREVIATIONS
µg Micro gram
HCN Hydrogen cyanide
IAA Indole acetic acid
NBRIP National Botanical Research Institute Phosphate
P Phosphorous
PSB Phosphate solubilizing bacteria
PSM Phosphate solubilizing Microorganisms
SEM Scanning Electron Microscope
TCP Tri calcium phosphate
10. REFERENCES
1. Kalayu G. Phosphate solubilizing microorganisms: promising approach as biofertilizers Int J Agron 2019;2019:1–7. CrossRef
2. Sharma SB, Sayyed RZ, Trivedi MH, Gobi TA. Phosphate solubilizing microbes: sustainable approach for managing phosphate deficiency in agricultural soils. Springerplus 2013;2:587. CrossRef
3. Sawyer J, Creswell J. Integrated crop management: in phosphorous basics. Iowa State University, Ames, Iowa, pp 182–3, 2000.
4. Illmer P, Schinner F. Solubilization of inorganic calcium phosphates solubilization mechanism. Soil Biol Biochem 1995;27:257–63. CrossRef
5. Omar SA. The role of rock phosphate-solubilizing fungi and Vascicular-arbuscular- mycorrhiza (VAM) in growth of wheat plants fertilized with Rock phosphate. World J Microbiol Biotechnol 1998;14:211–8. CrossRef
6. Nandimath AP, Karad DD, Gupta SG, Kharat AS. Consortium inoculum of five thermotolerant phosphate solubilizing actinomycetes for multipurpose biofertilizer preparation. Iran J Microbiol 2017;9(5):295–304.
7. Goldstein AH. Bacterial solubilization of mineral phosphate: Historical perspectives and future prospects. Am J Alter Agric 1986;1:51–7. CrossRef
8. Park KH, Lee OM, Jung HI, Jeong JH, Jeon YD, Hwang DY, et al. Rapid solubilization of insoluble phosphate by a novel stress-tolerant Burkholderia vietnamiensis M6 isolated from ginseng rhizospheric soil. Appl Microbiol Biotechnol 2010;86:947–55. CrossRef
9. Kibrom FG, Alemayehu N, Prakasan VR, Kiros W. Isolation and characterization of efficient phosphate solubilizing Bacillus (PSB) from different agro-ecological zones of tigray soil, Ethiopia. Momona Ethopian J Sci 2017;9(2):262–73. CrossRef
10. Lee KE, Adhikari A, Kang SM, You YH, Joo GJ, Kim JH, et al. Isolation and characterization of hidh silicate and phosphate solubilizing novel strain Enterobacter ludwigi GAK2 that promotes growth in rice plant. Agronomy 2019;9(3):144. CrossRef
11. Richardson AE. Prospects for using soil microorganisms to improve acquisition of phosphorous by plants. Aust J Plant Physiol 2001;28:897–906. CrossRef
12. Deepa CK, Dastageer SG, Ashok Pandey. Isolation and characterization of plant growth promoting bacteria from non-rhizospheric soil and their effect on cowpea( Vigna Unguiculata (L.) Walp.) seedling growth. World J Microbiol Biotechnol 2010;26:1233–40. CrossRef
13. Gyaneshwar P, Naresh Kumar G, Parekh LJ. Effect of buffering on the phosphate solubilizing ability of microorganisms. World J Microbiol Biotechnol 1998;14:669–73. CrossRef
14. Harrold SA, Tabatabai MA. Release of inorganic phosphate from soil by low molecular weight organic acids. Common Soil Sci Plant Ann 2016;37:1233–45. CrossRef
15. Chaiharu M, Lumyong S. Phosphate solubilizing potential and stress tolerance of rhizobacteria from soil rice in Northen Thailand. World J Microbiol Biotechnol 2009;25:305–14. CrossRef
16. Tsegaye Z, Gizaw B, Tefera G, Feleke A, Chaniyalew S, Alemu T, et al. Isolation and biochemical characterization of plant growth promoting (PGP) bacteria colonizing the rhizosphere of Tef crop during the seedling stage. Biomed J Sci Tech Res 2019;14(2):10586–97. CrossRef
17. Sharan A, Shikha, Darmwal NS, Gaur R. Xanthomonas compestris a novel stress tolerant, phosphate solubilizing bacterial strain from saline-alkali soils. World J Microbiol Biotechnol 2008;24:753–9. CrossRef
18. Johri JK, Surange S, Nautiyal CS. Occurrence of salt, pH and temperature-tolerant, phosphate solubilizing bacteria in alkaline soil. Curr Microbiol 1999;39:89–93. CrossRef
19. Ali SZ, Sandhya V, Rao LV. Isolation and characterization of drought-tolerant ACC deaminase and exopolysaccharide producing florescent Pseudomonas sp. Ann Microbiol 2013;64(2):493–502. CrossRef
20. Nautiyal CS. An efficient microbiological growth medium for screening phosphate solubilizing microorganisms. FEMS Microbiol Lett 1999;170:265–70. CrossRef
21. Edi Premono M, Moawad MA, Vleck PLG. Effect of phosphate solubilizing Pseudomonas putida on growth of maize and its survival in the rhizosphere. Indonesia J Crop Sci 1996;11:13–23.
22. Paul D, Sinha SN. Isolation and characterization of phosphate solubilizing bacterium Pseudomonas aeruginosa KUPSB12, with antibacterial potential from river Ganga, India. Annu Agranian Sci 2017;15:130–6. CrossRef
23. Deepa CK, Dastageer SG, Pandey A. Plant growth promoting activity in newly isolated Bacillus thioparus (N11-0902) from Western Ghat forest, India. World J Microbiol Biotechnol 2010;26:2277–83. CrossRef
24. Ames, BN. Assay of inorganic phosphate, total phosphate and phosphatases. Methods Enzymol 1964;8:115–8. CrossRef
25. Gorden SA, Weber RP. Colorimetric estimation of indole acetic acid. Plant Physiol 1951;2:192–5. CrossRef
26. Cappuccino JC, Sherman N. Microbiology: a laboratory manual. Benjamin/Cummings Pub. Co., New York, NY, pp 125–79, 1992.
27. Bakker AW, Shipper B. Microbial cyanide production in the rhizosphere in relation to potato yield reduction and Pseudomonas spp. mediated plant growth stimulation. Soil Biol Biochem 1987;19:451–7. CrossRef
28. Aneja KR. Experiments in microbiology, plant pathology, tissue culture and microbial biotechnology. 4th edition, New Age International Pvt Ltd Publishers, New Delhi, 2009.
29. Hendrick CW, Doyle JD, Hugley B. A new solid medium for enumerating cellulose utilising bacteria in soil. App Environ Microbiol 1995;61(5):2016–9. CrossRef
30. Praveen Kumar G, Hassan Ahmed SKM, Desai S, Daniel Amalraj EL, Rasul A. In vitro screening for abiotic stress tolerance in potent biocontrol and plant growth promoting strains of Pseudomonas and Bacillus spp. Int J Bacteriol 2014;2014:6. Available via http://dx.doi.org/10.1155/2014/195946 CrossRef
31. Soni A, Rokad S, Sharma P. Screening of efficient halo-tolerant phosphate solubilizing bacteria and their effect on seed germination under saline conditions. J Sci Innov Res 2013;2(5):932–7.
32. ISTA. Proceeding of international seed testing Association, International rules for seed testing. Seed Sci Technol 1999;21:25–30.
33. Holt JG, Krieg NR, Sneath PHA, Stanley JT, William ST. Bergeys manual of determinative bacteriology. 9th edition, Lippincott Williams and Willkins, Philadelphia, PA, 1994.
34. Rayes I, Bernier L, Antoun H. Rock phosphate solubilization and colonization of maize rhizosphere by wild and genetically modified strains of Pennicillium rugulosum. Microb Ecol 2002;44:39–48. CrossRef
35. Goldstein AH. Recent progress in understanding the molecular genetics and biochemistry of calcium phosphate solubilization by gram negative bacteria. Biol Agric Hortic 1995;12:185–93. CrossRef
36. Gupta R, Singal R, Shankar A, Kohad RC, Saxena RK. A modified plate assay for screening phosphate solubilizing microorganisms. J Gen App Microbiol 1994;40:255–60. CrossRef
37. Gulati A, Vyas P, Rahi P, Kasana RC. Plant growth promoting and rhizosphere Competent Acinetobacter rhizosperae strain B1HB 723 from the cold deserts of Himalayas. Curr Microb 2009;58:371–7. CrossRef
38. Sujatha VS, Nair AS, Nybe EV. Performance of different type of planting material in the rooting and establishment of Bush pepper. Indian J Hortic 2004;61:287–8.
39. Tiwari M, Ghosh A, Satyapal GK, Kumar A. Phosphate solubilization activity of bacterial strain isolated from Gangetic plains of North Bihar. IOSR J Biotechnol Biochem 2018;4(6):1–8.
40. Ivanova R, Boijnova D, Nedialkova K. Rock phosphate solubilization by soil bacteria. J Univ Chem Technol Metall 2006; 41:297–302.
41. Kishore N, Pindi PK, Reddy SR. Phosphate solubilizing microorganism: a critical review. Plant Biol Biotechnol 2015;1:307–33. CrossRef
42. Patten C, Glick BR. Bacterial biosynthesis of indole-3-acetic acid. Can J Microbiol 1996;42:207–20. CrossRef
43. Keymank HC, Yarali F, Guvenc I, Donmez MF. Effect of inoculation with plant growth promoting rhizobacteria (PGPR) on root formation of mint (Mentha piperita L.) cutting. Afri J Biotechnol 2008;87:283–307.
44. Goswami D, Dhandukhi P, Patela P, Thakkera JN. Screening of PGPR from saline desert of Kutch: growth promotion in arachis hypogea by Bacillus licheniformis A2. Microbiol Res 2014;169(1):66–75. CrossRef
45. Jha CK, Annapurna K, Saraf M. Isolation of rhizobacteria from Jatropha curcas and characterization of produced ACC deaminase. J Basic Microbiol 2012;52:285–95. CrossRef
46. Wani PA, Khan MS. Bacillus species enhanced growth parameters of chickpea (Cicer arietinum L) in chromium stressed soil. Food Chem Toxicol 2010;48:3262–7. CrossRef
47. Pacome AN, Kochoni E, Didagbé YO, Adjanohoun A, Allagbé M, Sikirou R, et al. Effect of different plant growth promoting rhizobacteria on Maize seed germination and Seedling development. Am J Plant Sci 2013;4:1013–21. CrossRef
48. Patil VS. Bacillus subtilis: A potential salt tolerant phosphate solubilizing bacterial agent. Int J Life Sci Biotechnol Pharma Res 2004;3(2):141–5.
49. Potts M. Dessication tolerance of prokaryotes. Microbiol Rev 1994;58:755–805. CrossRef
50. Meena KK, Sorty AM, Bitla UM, Choudhary K, Gupta P, Pareek A, et al. Abiotic stress response and microbe- mediated mitigation in plants. The omics strategies. Front Plant Sci 2018;8(Article 172):1–25. CrossRef
51. Gaind S, Gaur AC. Thermotolerant phosphate solubilizing microorganisms and their interaction with mung bean. Plant Soil 1991;133:141–9. CrossRef
52. Akbaruddin S. Alkalinity and Salinity bane of soil in T state. Times of India, Mumbai, India, 2015.
53. Surange S, Wollum II, Kumar AG, Kumar N, Nautiyal CS. Characterization of rhizobium from root nodules of leguminous trees growimg in alkaline soil. Can J Microbiol 1997;43:891–4. CrossRef
54. Kausar A, Gull M. Influence of salinity stress on the uptake of magnesium, phosphorous and yield of salt susceptible and tolerant Sorghum cultivars (Sorghum bicolor L). J App Biol Biotech 2019;7(03):53–8. CrossRef
55. Sharma SR, Rao NK, Gokhale TS, Ismail S. Isolation and characterization of salt tolerant rhizobia native to the desert soil of United Arab Emirates. J Food Agric 2013;25(2):102–8. CrossRef
56. Mohan V, Saranya Devi K, Anushya A, Revathy G, Viji Kuzhalvaimozhi G, Vijayalakshmi KS. Screening of salt tolerant and growth promotion efficacy of phosphate solubilizing bacteria. J Acad Ind Res 2017;5:168–72.
57. Saitou N, Nei M. The neighbor- joining method. A new method for reconstructing phylogenetic tree. Mol Biol Evol 1987;4(4):406–25.
58. Felsentein J. Phylogenesis and the comparative method. Am Nat 1985;125(1):1–15. CrossRef
59. Kimura M. A simple method of estimating evolutionary rates of base substitution through comparative studies of nucleotide sequences. J Mol Evol 1980;16:111–20. CrossRef
60. Kumar S, Stecher G, Tamura K. MEGA 7: molecular evolutionary genetic analysis- version 7.0 for bigger databases. Mol Bio Evol 2016;33(7):1870–74. CrossRef